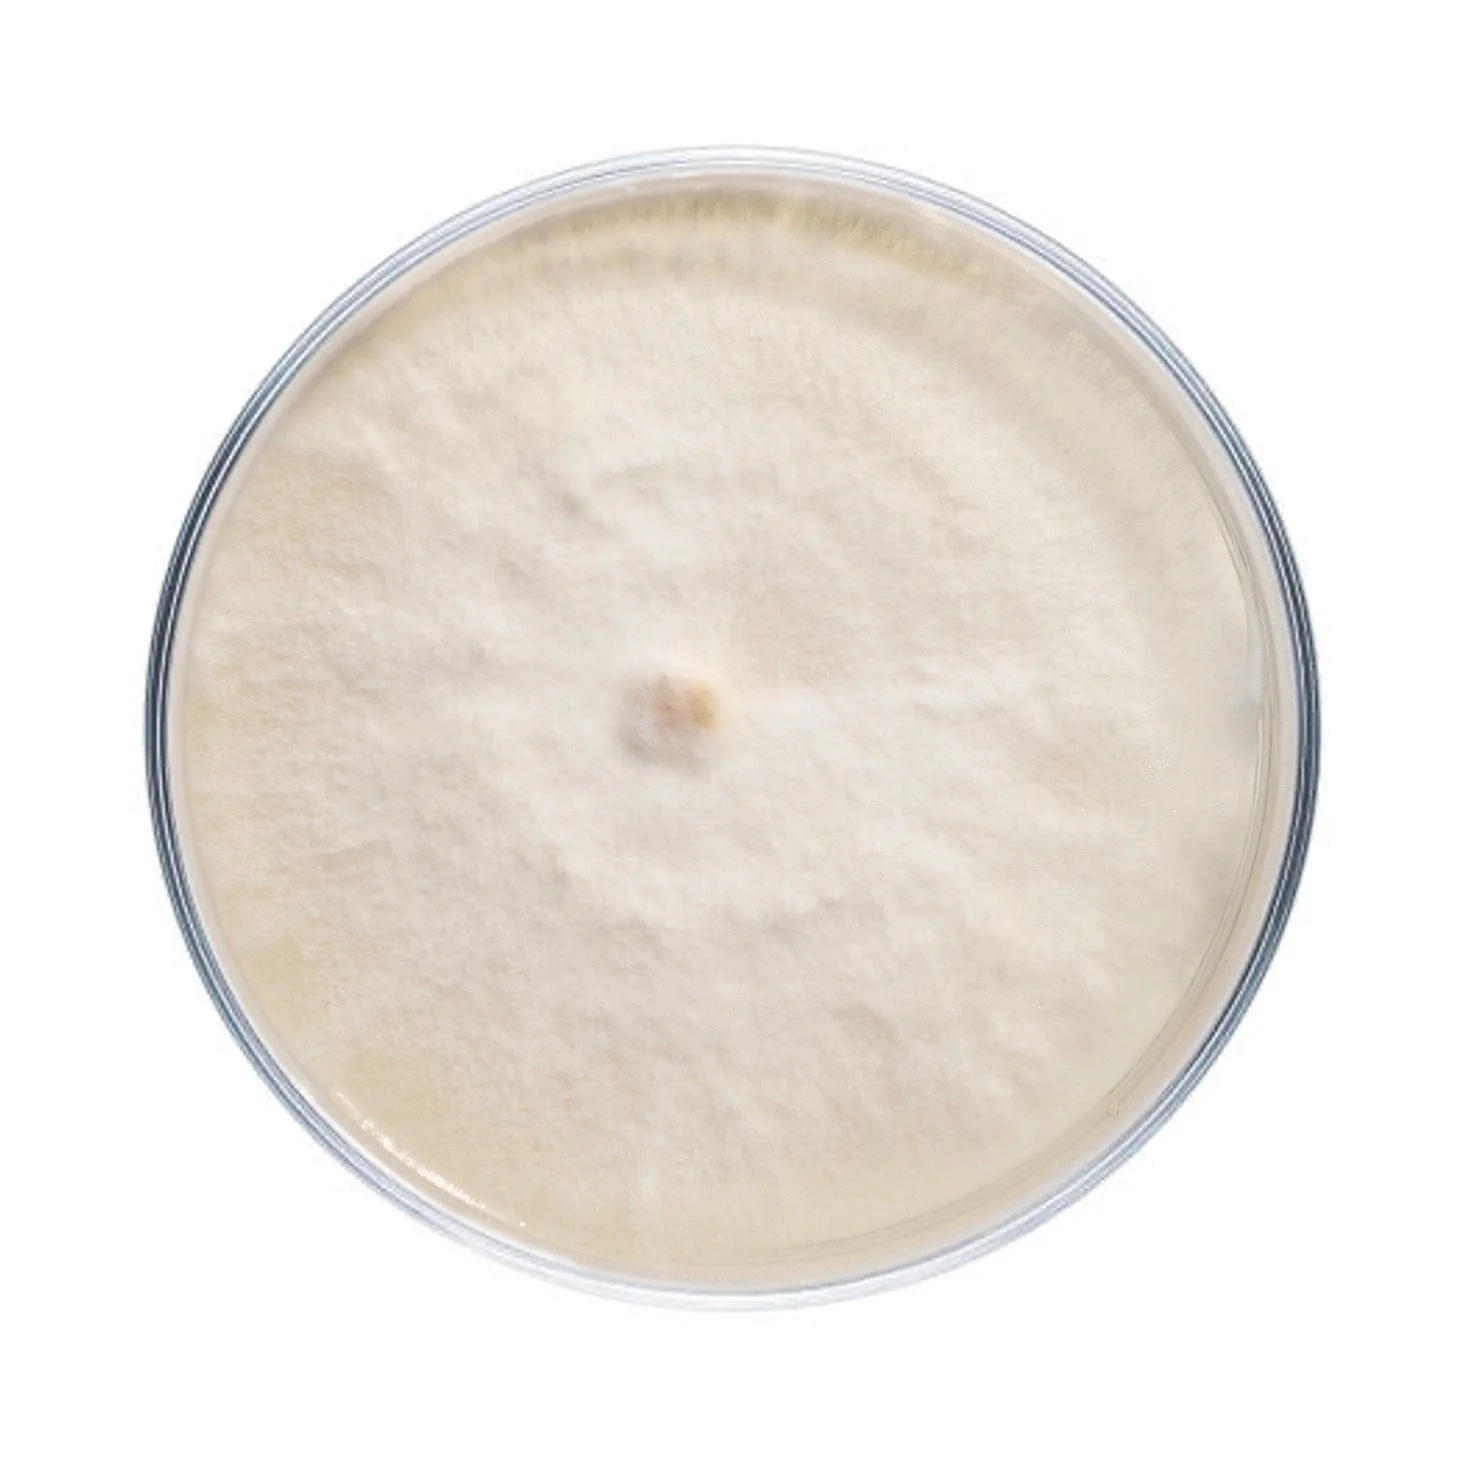
Product image 4

Nameko Mushroom Plate Culture
Plates cultures are ideal for growers looking to make master bags, inoculate grain, make liquid culture, or make more plates.
Our nameko plates are made to order in our in-house lab using medical-grade petri dishes. If properly stored upon arrival, they have a shelf life of approximately 6 months. Nameko plates should be stored in the refrigerator to maintain viability. Note that mycelium cultures require basic lab skills. Handle using sterile technique to prevent contamination.
For complete descriptions of available nameko strains, click on the names below.
NSPN1 - 'Jelly Roll' Pholiota nameko
- A good indoor producer that will make copious amounts of the nameko mushroom's quintessential gelatinous coating when grown with proper humidity. Needs cooler temperatures to fruit!
Original: $74.99
-70%$74.99
$22.50Product Information
Product Information
Shipping & Returns
Shipping & Returns
Description
Plates cultures are ideal for growers looking to make master bags, inoculate grain, make liquid culture, or make more plates.
Our nameko plates are made to order in our in-house lab using medical-grade petri dishes. If properly stored upon arrival, they have a shelf life of approximately 6 months. Nameko plates should be stored in the refrigerator to maintain viability. Note that mycelium cultures require basic lab skills. Handle using sterile technique to prevent contamination.
For complete descriptions of available nameko strains, click on the names below.
NSPN1 - 'Jelly Roll' Pholiota nameko
- A good indoor producer that will make copious amounts of the nameko mushroom's quintessential gelatinous coating when grown with proper humidity. Needs cooler temperatures to fruit!






















